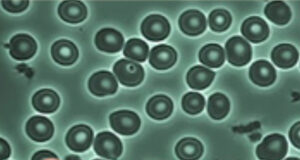

血液ドロドロは危ない!!(肺血栓塞栓症)

こんにちは!!HEALBO博士です🧐
梅雨真っただ中の梅雨の中休みですが、蒸し蒸しして暑いです😖
血液ドロドロは危ない!!(肺血栓塞栓症)
友人が胸が痛いと言っていたので、昔の自分を思い出しました😂
HEALBOと出会う前の私は、あまり水を飲まず、飲み物はコーヒー☕か
お酒でした。激しい運動や体が疲れている時に急に胸が痛くなる事がありました。
その当時、病院に行ったときにお医者さんに「水を良く飲みなさい」と言われ
ました。理由は、血液がドロドロになってるからと言われました!!
水分を取らなすぎるのとお酒は水分ではない
水分はあまり取ってなかったのですが、仕事が終わって唯一の楽しみが待って
いました🍺
それは、お酒(ビール)を飲むことでした。結構な量を飲んでいたいので、水分
は取っていると感じていたのですが、アルコールと水は吸収され方が違うから、
水分として入れたらダメとお医者様に言われてビックリ😲
赤血球(酸素を運ぶ血液)が連鎖(凝集)する!
水分が少ないとドロドロの血液になって酸素を運ぶ赤血球と呼ばれる血液が連鎖
(凝集)するそうです!!その為、同じ血液でもドロドロとサラサラの血液では
酸素を体全体に運べる量が違うんですね!!
血液がドロドロだと血栓症になる可能性が多くなり、血栓が剥がれて血管が詰まる
と心筋梗塞等になるそうです😖
水の浸透率を上げて吸収しやすいHEALBO改質水💧
血液ドロドロ (赤血球が連鎖している状態)

血液サラサラ(赤血球が拡散している状態)
HEALBO改質水は、酸素を多く含んで浸透率が上がる水に改質されます。
なので、赤血球がドロドロからサラサラになって酸素を一杯運べる血液になる
んですよ!!
血液をサラサラにしてくれる→→HEALBO
関連情報
